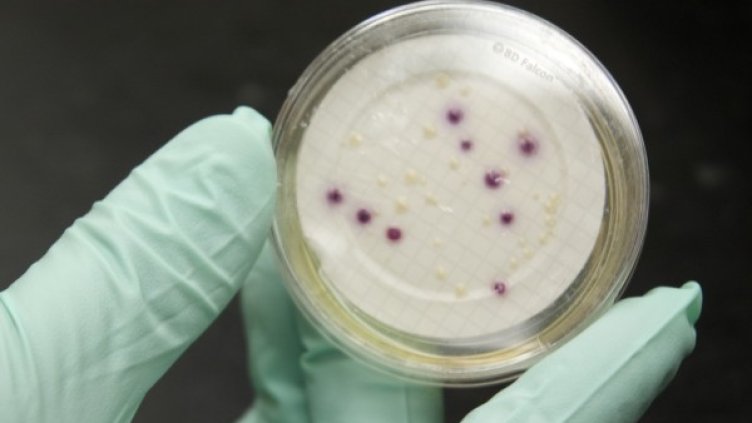
Снимка: Reuters

Бактерии, станали резистентни към последното поколение антибиотично лечение, могат да предизвикат глобална епидемия, съобщава британският вестник "Индипендънт", цитирайки откритие на китайски учени.
Ген направил бактерията резистентна към полимиксини, на които лекарите разчитат в лечението, когато всяко друго завърши без успех.
Налице е "изключително тревожно" доказателство, че генът може да направи бактериите супер устойчиви, което ще доведе до сериозни епидемии.
Учените са открили щамове на E.coli и други заболявания, които могат да причинят сериозни инфекции и дори смърт. Един щам на E.coli е показал резистентност към колистин по време на рутинни тестове в Шанхай.
Учените са открили, че бактерията може да прехвърля имунитета си към лекарството към други вирусни щамове чрез гена mcr -1.
Резултатите наложили провеждането на по-нататъшни тестове на бактериални проби в кланици за свинско и пилешко месо в четири китайски провинции. Високо разпространение на гена, причиняващ резистентност, е намерено при бактерията E. Coli, изолирана от животни, суровинни и месни проби.
Обезпокоително е, че този ген се разпространява все повече от година на година, алармираха учените след изследвания между 2011 и 2014 г.
Според водещия автор на изследването Джин Хуа Лиу от университета в Гуанджоу това са изключително обезпокоителни резултати. Колистинът е полимиксен антибиотик, който се използва в селското стопанство, а колкото по-често се употребява, толкова повече ще се разпространява генът, водещ до резистентност.
Това се случи Dnes, за важното през деня ни последвайте и в Google News Showcase.

Bloomberg TV Bulgaria и Bulgaria ON AIR излъчват церемонията Real Estate Awards 2026
Bloomberg TV Bulgaria и Bulgaria ON AIR излъчват церемонията Real Estate Awards 2026  Кадър на деня за 5 юли
Кадър на деня за 5 юли  AI компаниите се борят за властта на правителствата
AI компаниите се борят за властта на правителствата  Москва дава рекордни субсидии на петролните компании, докато рафинериите им горят
Москва дава рекордни субсидии на петролните компании, докато рафинериите им горят  Китайските автомобилни марки отиват в Канада като подготовка за навлизане в САЩ
Китайските автомобилни марки отиват в Канада като подготовка за навлизане в САЩ  ОПЕК+ се разбраха за ново умерено увеличение на добивите през август
ОПЕК+ се разбраха за ново умерено увеличение на добивите през август 
 Протести срещу свръхтуризма в Са Рапита, Майорка (СНИМКИ)
Протести срещу свръхтуризма в Са Рапита, Майорка (СНИМКИ)  Централна прогноза
Централна прогноза  Никола Цолов: В момента никой не може да ме спре
Никола Цолов: В момента никой не може да ме спре  Забранено е къпането в Струма в дефилето между Невестино и Бобошево
Забранено е къпането в Струма в дефилето между Невестино и Бобошево  Загадките на древността: Забравеният храм на Хермес в Средна гора
Загадките на древността: Забравеният храм на Хермес в Средна гора  Папа Лъв ХІV излиза в лятна ваканция
Папа Лъв ХІV излиза в лятна ваканция 
 Червен триумф! Льоклер зарадва Ферари, след драма с Кими Антонели
Червен триумф! Льоклер зарадва Ферари, след драма с Кими Антонели  Ман Юнайтед пазарува от Челси
Ман Юнайтед пазарува от Челси  Край на търпението: Левски се разделя с трансферна издънка
Край на търпението: Левски се разделя с трансферна издънка  Шампион отряза Левски
Шампион отряза Левски  Разкриха заплатата на Стефано Сенси в ЦСКА – взима повече от Лиъм Купър
Разкриха заплатата на Стефано Сенси в ЦСКА – взима повече от Лиъм Купър  Донски гази в Яш
Донски гази в Яш 
 Дневен хороскоп за 6 юли, понеделник
Дневен хороскоп за 6 юли, понеделник  Поверия за ангелската дата 7/7
Поверия за ангелската дата 7/7  Седмичен хороскоп за 6 – 12 юни: Успех с парите за Козирозите
Седмичен хороскоп за 6 – 12 юни: Успех с парите за Козирозите  Хората, които винаги виждат най-доброто в някого, пропускат тези 4 червени флага
Хората, които винаги виждат най-доброто в някого, пропускат тези 4 червени флага  Поверия за Летен Атанасовден
Поверия за Летен Атанасовден  Задължителни ястия за Летен Атанасовден
Задължителни ястия за Летен Атанасовден 
 продава, Хотел, 461 m2 Габрово област, с.Кметовци, 240000 EUR
продава, Хотел, 461 m2 Габрово област, с.Кметовци, 240000 EUR  продава, Парцел, 8600 m2 София, Връбница 1, 3870000 EUR
продава, Парцел, 8600 m2 София, Връбница 1, 3870000 EUR  продава, Парцел, 4871 m2 София, Драгалевци, 1217750 EUR
продава, Парцел, 4871 m2 София, Драгалевци, 1217750 EUR  продава, Четиристаен апартамент, 306 m2 София, Лозенец, 972000 EUR
продава, Четиристаен апартамент, 306 m2 София, Лозенец, 972000 EUR  продава, Къща, 230 m2 София област, гр. Елин Пелин, 580000 EUR
продава, Къща, 230 m2 София област, гр. Елин Пелин, 580000 EUR  продава, Парцел, 1440 m2 София област, гр. Долна Баня, 22500 EUR
продава, Парцел, 1440 m2 София област, гр. Долна Баня, 22500 EUR 
 Съветник на Илияна Йотова спаси дете в Гърция
Съветник на Илияна Йотова спаси дете в Гърция  Времето утре ще бъде предимно слънчево
Времето утре ще бъде предимно слънчево  От 1 август: Вдигат доходния праг за получаване на детски надбавки
От 1 август: Вдигат доходния праг за получаване на детски надбавки  Изтича старият петгодишен договор за сметопочистването на Варна
Изтича старият петгодишен договор за сметопочистването на Варна  Президентката на Словения критикува косвено българското блокиране на РСМ
Президентката на Словения критикува косвено българското блокиране на РСМ  Български туристи преживяха напрегнати моменти край Лефкада
Български туристи преживяха напрегнати моменти край Лефкада 
 Книгата, която обясни Вселената: „Математически начала на натуралната философия“
Книгата, която обясни Вселената: „Математически начала на натуралната философия“  Уловиха „шепота“ на всички звездни експлозии във Вселената
Уловиха „шепота“ на всички звездни експлозии във Вселената  Еверест отстъпва: Кои са най-опасните върхове в света?
Еверест отстъпва: Кои са най-опасните върхове в света?  Преди 400 г. художник е изобразил феномен, който науката e потвърдила едва наскоро
Преди 400 г. художник е изобразил феномен, който науката e потвърдила едва наскоро  Малка бактериална тайна може да доведе до по-добри лекарства срещу рак
Малка бактериална тайна може да доведе до по-добри лекарства срещу рак  НАСА с необичайно обещание: Футболна топка ще лети до Луната, ако САЩ спечелят световното първенство
НАСА с необичайно обещание: Футболна топка ще лети до Луната, ако САЩ спечелят световното първенство 












